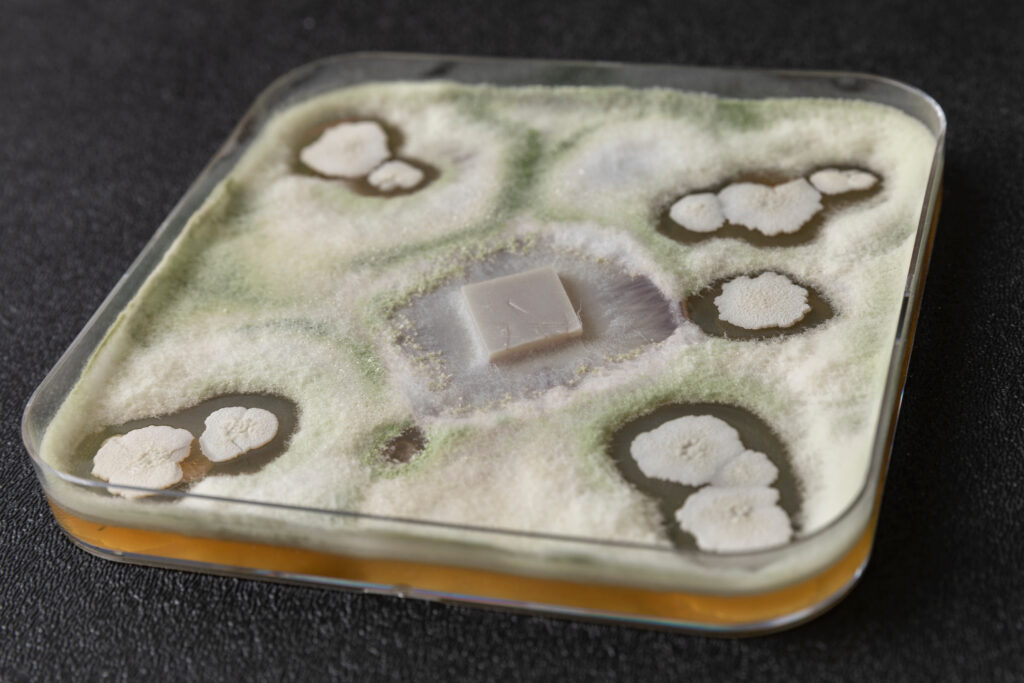

A deep dive into innovation, regulatory frameworks, technical performance and global market momentum.
Biological seed treatments are rapidly reshaping how the global seed sector approaches crop resilience, sustainability, and regulatory change. As pressures mount on conventional chemistries and growers face increasingly unpredictable conditions, biologicals are emerging as vital tools that complement, and in some cases enhance, the performance of traditional seed treatments. This article brings together insights from four leading companies to explore the practical relevance, challenges, regulatory gaps, and farmer adoption trends shaping this fast-evolving field. Their perspectives reveal both the complexities and the considerable opportunities that biologicals present for industry and policymakers alike. What follows is a grounded, forward-looking examination of where biological seed treatments stand today, and where they may lead agriculture in the decade ahead.
The Growing Role of Biological Seed Treatments in Modern Agriculture
Across seed innovation centres worldwide, biologicals are steadily moving from experimental additions to essential components of modern seed treatment strategies. Their appeal lies not in replacing conventional chemistries, but in expanding what seed-applied solutions can deliver — especially as growers contend with more frequent climate extremes and tighter regulatory expectations.

At BASF, this trend is reflected in how biologicals are being positioned within treatment packages. Rob Gaffney, BASF director global marketing seed treatments – global key accounts, explains that these products enhance root development, nutrient uptake, and stress tolerance, complementing rather than competing with traditional tools. This integrated approach aligns with growers’ growing interest in resilience and sustainability.
A similar evolution is evident at Corteva Agriscience. Biologicals are becoming more than an optional add-on; they increasingly serve as integral components of broader agronomic systems. Christine Hazel, Corteva’s global regulatory lead – Seed Applied Technology, notes that these seed-applied biologicals support both sustainability goals and integrated pest management, making them important in regions where environmental stewardship is becoming a key decision factor for farmers.
The shift is just as pronounced at Bayer, where biologicals are being woven into a much larger tapestry of innovation. Rather than viewing products in isolation, the company focuses on complete, solutions. According to Steve Bäsel, senior regulatory policy manager at Bayer, growers are combining traditional chemistries, biologics, seed germplasm, and digital insights to create holistic, performance-driven systems. Biologicals, he adds, also offer meaningful contributions to soil-health-related sustainability.
At Incotec, the expanding toolbox of biologicals is reshaping seed treatment practices in multiple directions. Biofertilizers once used primarily in legumes are now steadily moving into crops like maize, while biostimulants slot naturally into existing seed treatment stacks. Rob Pronk, global marketing manager and global regulatory manager at Incotec, notes that biopesticides can either complement conventional treatments or, in certain cases, replace them altogether — highlighting how biologicals are diversifying the role of seed-applied technologies across crops and regions.


Challenges and Barriers in Developing and Commercializing Biologicals
Despite their promise, biological seed treatments face a demanding road to market. The biological innovation cycle is fast — and Bäsel notes that this dynamism makes it difficult for large companies to align pipeline development with short- and mid-term portfolio needs. Bayer has responded with an Open Innovation model that relies on partnerships with smaller innovators and technology leaders to keep pace with market demand.


Regulation, however, remains the biggest structural barrier. Across many regions, biologicals are evaluated using frameworks originally designed for chemicals, which can result in long timelines, high fees, and uncertainty — especially for new microbial technologies or gene-edited strains. “The absence of specific pathways for biologicals creates delays and complexity,” Bäsel explains. This is further compounded by competitive market conditions and lingering grower scepticism fuelled by inconsistent performance of early-generation products.
On the technical side, Pronk stresses the difficulty of maintaining product efficacy throughout the seed’s shelf life. Biologicals must survive formulation, seed application, storage, and downstream handling while still performing in the field. Compatibility inside increasingly complex seed treatment stacks is equally critical.
From a regulatory standpoint, Hazel highlights the dual challenge of stability and data requirements. For biopesticides, the regulatory pathways are somewhat more aligned globally, but still heavily data driven. Biostimulants and biofertilizers, however, operate in “a more complex and evolving regulatory space,” with requirements varying widely by country. Meanwhile, lack of harmonized standards continues to slow commercialization.
Gaffney underscores that product consistency is essential for rebuilding grower trust. Extensive pre-commercial testing is needed to ensure seed safety, environmental safety, compatibility with other treatments, and performance across geographies and seed-treatment processes. The industry is rising to meet these expectations, but the bar is high.


Why Global Regulatory Harmonization Matters for Biological Seed Treatments
Given this fragmented global landscape, clearer guidance and shared terminology have become essential. Gaffney sees the ISF Guide for Biologicals as a practical step forward. By aligning definitions and product classifications, the guide supports advocacy for science-based and risk-proportionate regulation. It also helps facilitate trade and enables companies to build internal compliance systems around common principles.
For Bäsel, the guide’s value lies in creating a shared language. When regulators and industry speak consistently about biologicals — what they are, what they do, and how they should be evaluated — communication improves across borders. Understanding the regulatory landscape in other regions, he notes, is critical for companies operating globally, and the guide provides a structured way to do exactly that.

What Drives Farmer Adoption of Biological Seed Treatments?
Farmer adoption ultimately depends on trust — and trust depends on results. Pronk believes that setting realistic expectations is fundamental. Biologicals are powerful tools, but they must be understood and used appropriately to succeed.


Performance and return on investment remain top priorities for growers. Bäsel points to Bayer’s new biological bird repellent, Ibisio®, as an example of innovation meeting farmer needs. Made from Black Pepper Oleoresin, this product provides a strong environmental profile while matching market standards for early season seed protection. Emergency authorizations across several European markets are already giving farmers hands-on experience with the product.
Bayer’s long-running biological success story, Serenade®, reinforces the importance of consistency. Powered by Bacillus amyloliquefaciens strain QST713, this product has earned global confidence through reliable performance, compatibility with IPM, pollinator friendliness, and soil health benefits — qualities that growers increasingly value.
At Corteva, Hazel highlights biologicals such as Poncho® Votivo®, which combines a chemical insecticide with a biological nematicide to deliver healthier stands and an average 5.1 bu/A yield advantage in corn compared to chemical-only treatments. Another example is Lumialza®, which colonizes the root zone to form a biological barrier against nematodes and has shown a 3.7 bu/A yield benefit even in low-pressure environments. These results, Hazel notes, reinforce growers’ understanding that biologicals can be both sustainable and highly effective.
The Future of Biologicals: Market Growth, Innovation, and Global Guidance
Looking ahead, the experts see biological seed treatments accelerating in both adoption and importance. Gaffney envisions a future shaped by rising expectations for sustainability, increasing regulatory complexity, and the need for more diverse modes of action.


Shared definitions, science-based evaluation, and clear communication will be crucial to unlocking their potential.
Hazel emphasizes that global guidance — such as the guide — will help align stakeholders, enable collaboration, and encourage more consistent regulatory pathways.
These elements will be critical for speeding innovation and bringing new biologicals to market.
Meanwhile, Bäsel expects significant market expansion in the coming years. He notes that the EMEA market for biocontrol and biostimulants is projected to double by 2030, reaching €8 billion. Industry-wide efforts to educate growers, policymakers, and value-chain partners will be essential to sustaining this growth. “The guide will serve as a valuable educational resource,” he adds, helping raise awareness of biological seed treatments and the innovations driving them forward.
A New Era for Seed-Applied Innovation
Biological seed treatments are reshaping the seed sector’s innovation landscape. They bring new modes of action, support IPM, improve soil health, and create more resilient cropping systems — all while aligning with global sustainability goals. Yet they also face considerable challenges: variable regulations, technical hurdles, and lingering scepticism. Through harmonization efforts, scientific rigor, and effective communication, the seed sector has a real opportunity to accelerate biological adoption and unlock unprecedented value for growers.
As agriculture confronts climate, regulatory, and sustainability pressures, biologicals are poised to become an indispensable part of the seed treatment toolbox — strengthening seeds, supporting farmers, and expanding the future possibilities of sustainable crop production.






